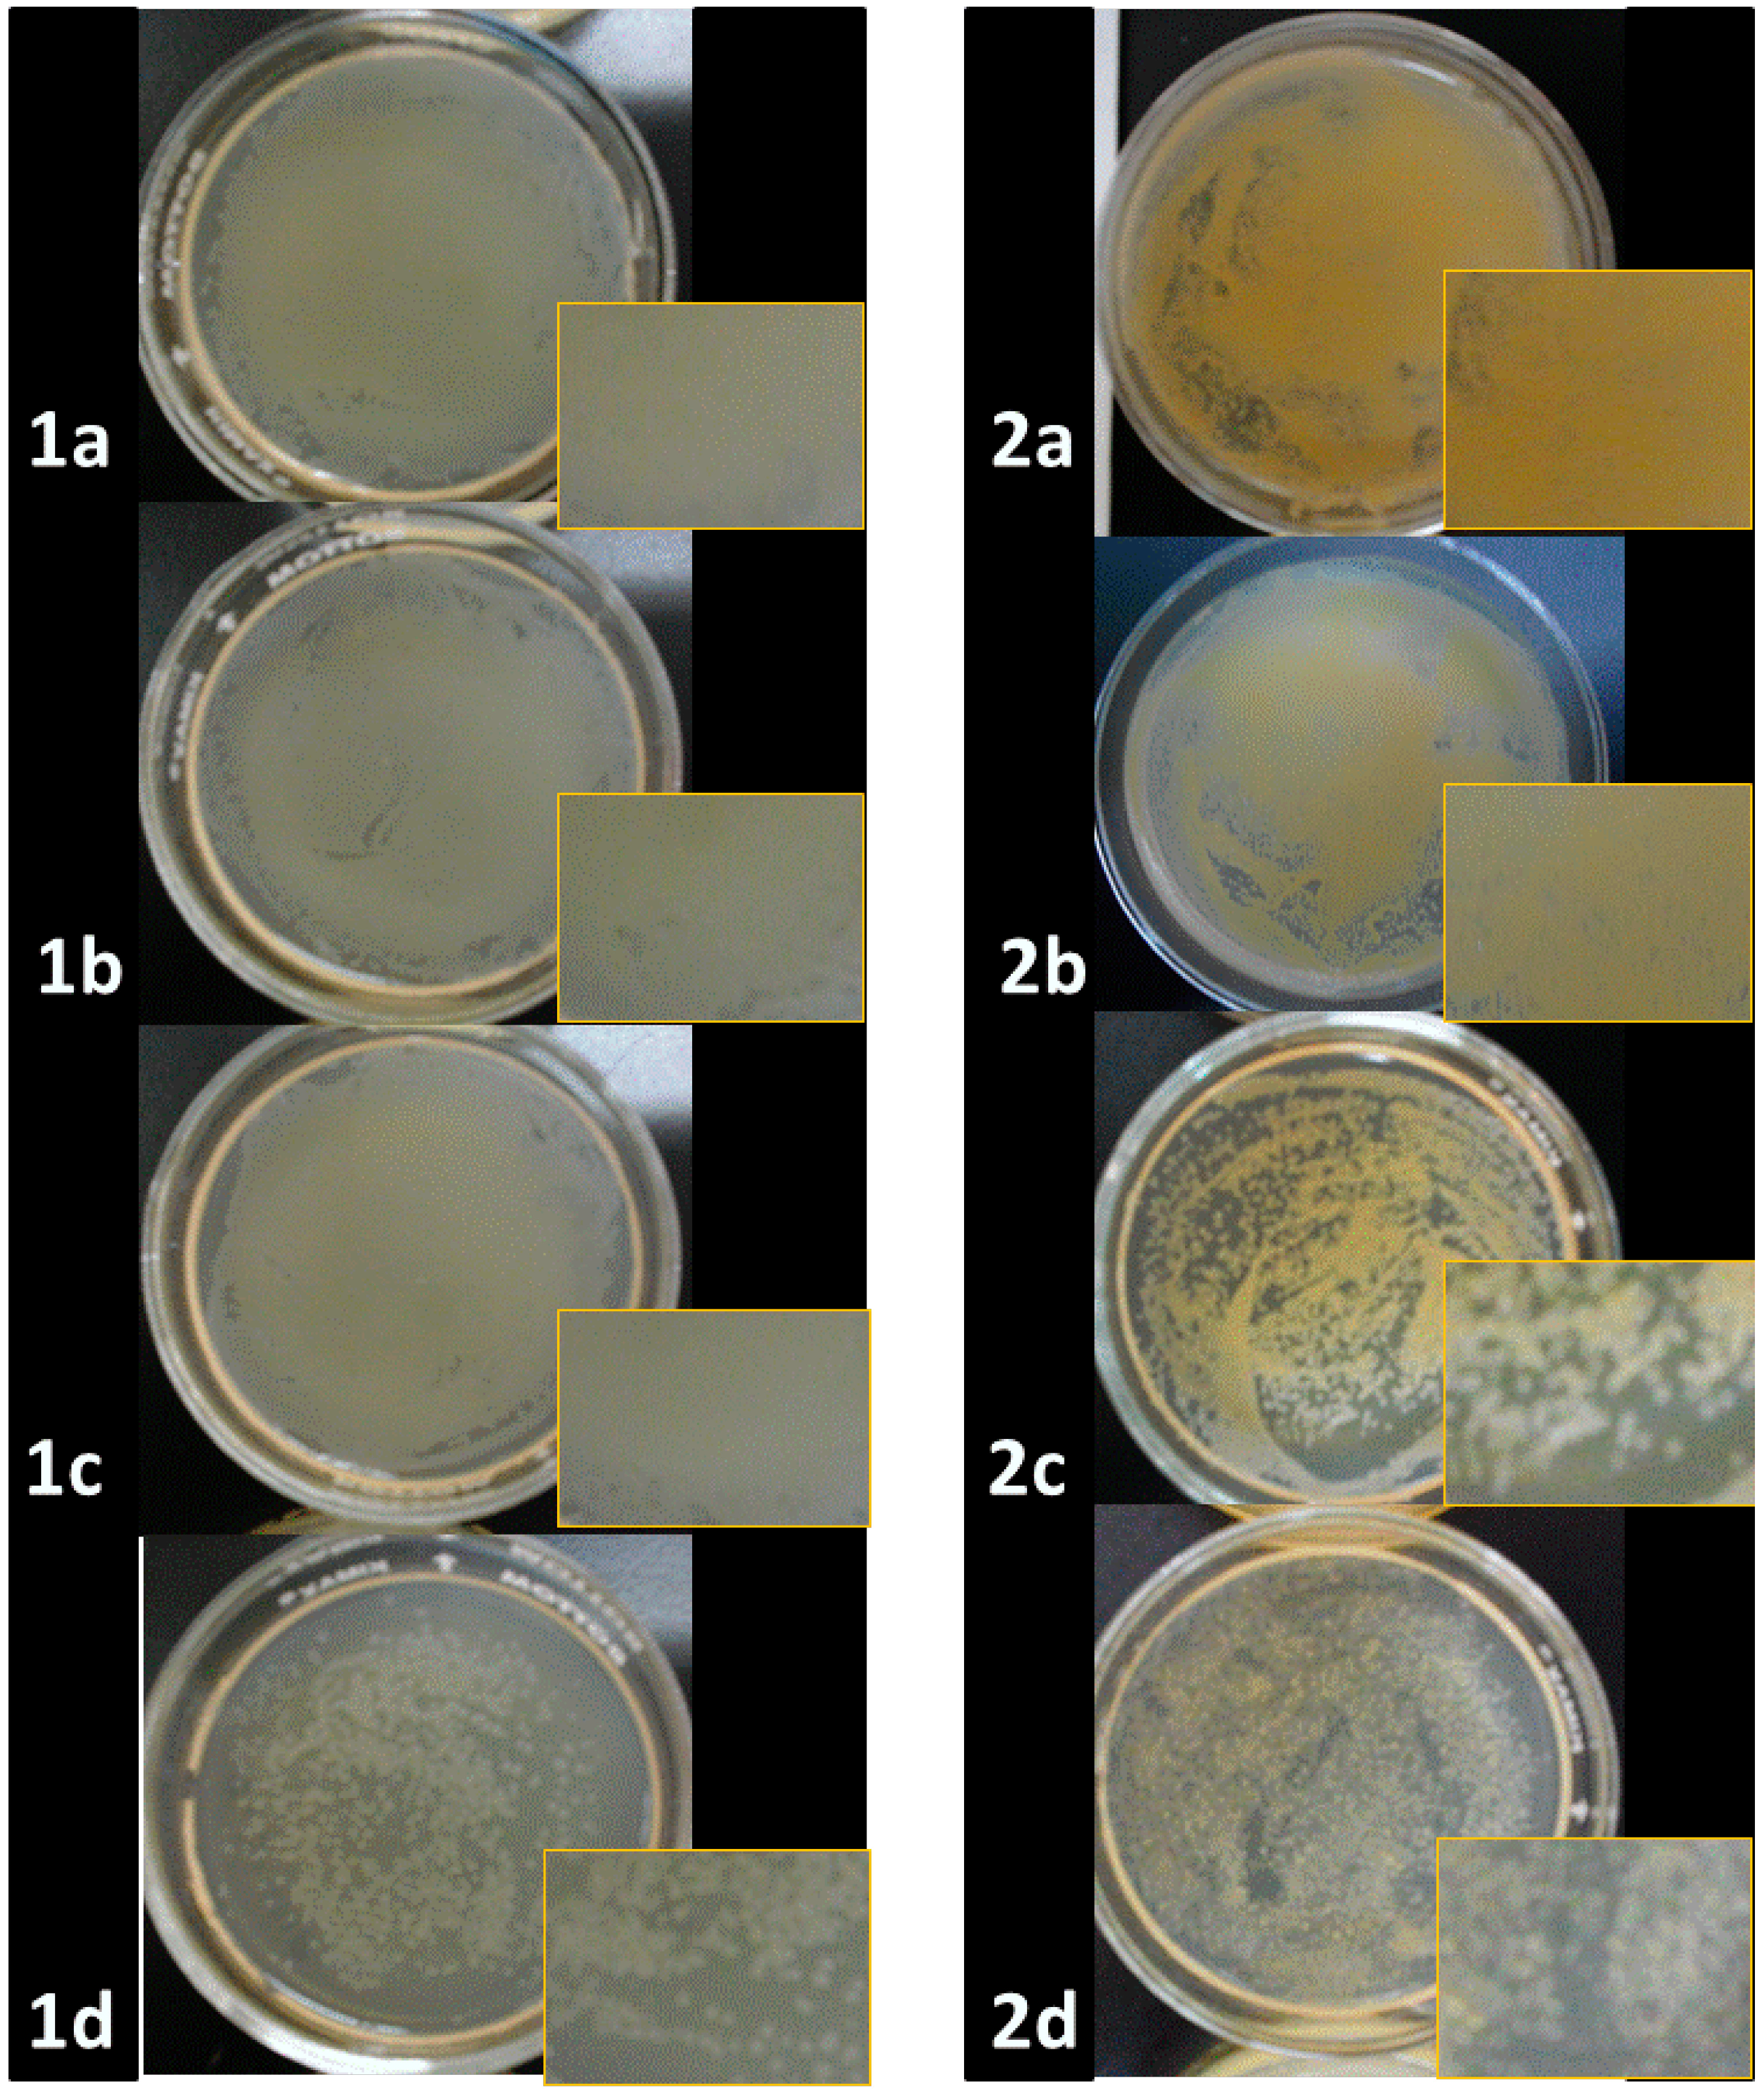
Molecules 20 06002 g006

Organic-Inorganic Hybrid Nanoparticles for Bacterial Inhibition: Synthesis and Characterization of Doped and Undoped ONPs with Ag/Au NPs
Abstract
:1. Introduction
2. Results and Discussion



2.1. Optical Properties of ONPs, ONPs/Ag and ONPs/Au

2.2. Antibacterial Activities of ONPs, ONPs/Ag and ONPs/Au

| Inhibitor | Minimal Inhibitory Concentration (MIC) [44] [mmol/L] | |||
|---|---|---|---|---|
| Gram (+) | Gram (−) | |||
| Bacillus. cereus | Staphylococcus aureus | Escherichia coli | Salmonella typhi | |
| ONPs | 0.31 ± 0.04 | 0.39 ± 0.03 | 0.39 ± 0.05 | 0.39 ± 0.04 |
| ONPs/Ag | 0.26 ± 0.05 | 0.26 ± 0.05 | 0.22 ± 0.02 | 0.22 ± 0.03 |
| ONPs/Au | 0.39 ± 0.11 | 0.44 ± 0.02 | 0.44 ± 0.09 | 0.44 ± 0..04 |
| Ag-NPs | 0.17 ± 0.04 | 0.17 ± 0.03 | 0.13 ± 0.01 | 0.13 ± 0.05 |
| Au-NPs | 1.76 ± 0.05 | 1.82 ± 0.05 | 1.28 ± 0.07 | 1.12 ± 0.09 |

| Inhibition Zone Diameter (mm) * | |||||
|---|---|---|---|---|---|
| Material | Concentration [44] | Bacillus cereus | Staphylococcus aureus | Escherichia coli | Salmonella typhi |
| ONPs | 5.0 | NP | NP | NP | NP |
| ONPs/Ag | 5.0 | 7.0 ± 0.16 | 7.6 ± 0.12 | 9.3 ± 0.13 | 9.0 ± 0.10 |
| ONPs/Ag | 0.5 | 7.0 ± 0.11 | 8 ± 0.09 | 9.7 ± 0.12 | 9.3 ± 0.08 |
| ONPs/Au | 5.0 | 12.0 ± 0.21 | 11 ± 0.10 | 13 ± 0.14 | 13 ± 0.11 |
| Ag-NPs | 5.0 | - | - | - | - |
| Au-NPs | 5.0 | - | - | - | - |

2.3. Computational Procedure
| Molecular Orbital | Energy (eV) | ||
|---|---|---|---|
| LA | Ag-LA | Au-LA | |
| LUMO+3 | 0.001 | 0.490 | −0.288 |
| LUMO+2 | −0.027 | 0.005 | −0.620 |
| LUMO+1 | −0.310 | −0.599 | −2.637 |
| LUMO | −1.361 | −1.551 | −3.371 |
| ΔE(HOMO-LUMO) | 4.446 | 4.136 | 2.433 |
| HOMO | −5.807 | −5.687 | −5.804 |
| ΔE(HOMO-HOMO-1) | 1.951 | 0.272 | 0.822 |
| HOMO-1 | −7.758 | −5.959 | −6.626 |
| HOMO-2 | −8.073 | −6.476 | −7.227 |
| HOMO-3 | −8.696 | −7.456 | −7.978 |



3. Experimental Section
3.1. Materials and Methods
3.2. Equipment
3.3. Experimental Procedures: Organic Nanoparticles (ONPs)
3.4. Gold Doped-Organic Nanocomposites (ONPs/Au)
3.5. Silver-Organic Nanocomposites (ONPs/Ag)
3.6. Gold and Silver Nanoparticles
3.7. Standardization of Inoculum Suspension
3.8. Antibacterial Studies
3.9. Microbiological Qualitative Assays
3.10. Minimal Inhibitory Concentrations (MIC)
3.11. Morphological Analysis of Bacterial Cells Treatment with NPs
4. Conclusions
Supplementary Materials
Acknowledgments
Author Contributions
Conflicts of Interest
References
- Moritz, M.; Geszke-Moritz, M. The newest achievements in synthesis, immobilization and practical applications of antibacterial nanoparticles. Chem. Eng. J. 2013, 228, 596–613. [Google Scholar] [CrossRef]
- Singh, M.; Singh, S.; Prasad, S.; Gambhir, I.S. Nanotechnology in medicine and antibacterial effect of silver nanoparticles. Dig. J. Nanomater. Biostructures 2008, 3, 115–122. [Google Scholar]
- Feng, Q.L.; Wu, J.; Chen, G.Q.; Cui, F.Z.; Kim, T.N.; Kim, J.O. A mechanistic study of the antibacterial effect of silver ions on escherichia coli and staphylococcus aureus. J. Biomed. Mater. Res. 2000, 52, 662–668. [Google Scholar] [CrossRef] [PubMed]
- Lee, P.C.; Meisel, D. Adsorption and surface-enhanced Raman of dyes on silver and gold sols. J. Phys. Chem. 1982, 86, 3391–3395. [Google Scholar] [CrossRef]
- Lukman, A.I.; Gong, B.; Marjo, C.E.; Roessner, U.; Harris, A.T. Facile synthesis, stabilization, and anti-bacterial performance of discrete ag nanoparticles using medicago sativa seed exudates. J. Colloid Interface Sci. 2011, 353, 433–444. [Google Scholar] [CrossRef] [PubMed]
- Maillard, M.; Giorgio, S.; Pileni, M.P. Tuning the size of silver nanodisks with similar aspect ratios: Synthesis and optical properties. J. Phys. Chem. B 2003, 107, 2466–2470. [Google Scholar] [CrossRef]
- Cui, Y.; Zhao, Y.; Tian, Y.; Zhang, W.; Lü, X.; Jiang, X. The molecular mechanism of action of bactericidal gold nanoparticles on escherichia coli. Biomaterials 2012, 33, 2327–2333. [Google Scholar] [CrossRef] [PubMed]
- Arockiya Aarthi Rajathi, F.; Parthiban, C.; Ganesh Kumar, V.; Anantharaman, P. Biosynthesis of antibacterial gold nanoparticles using brown alga, stoechospermum marginatum (kützing). Spectrochim. Acta Part. A Mol. Biomol. Spectrosc. 2012, 99, 166–173. [Google Scholar]
- Muthuvel, A.; Adavallan, K.; Balamurugan, K.; Krishnakumar, N. Biosynthesis of gold nanoparticles using solanum nigrum leaf extract and screening their free radical scavenging and antibacterial properties. Biomed. Prev. Nutr. 2014, 4, 325–332. [Google Scholar] [CrossRef]
- Akhavan, O.; Ghaderi, E. Cu and cuo nanoparticles immobilized by silica thin films as antibacterial materials and photocatalysts. Surf. Coat. Technol. 2010, 205, 219–223. [Google Scholar] [CrossRef]
- Argueta-Figueroa, L.; Morales-Luckie, R.A.; Scougall-Vilchis, R.J.; Olea-Mejía, O.F. Synthesis, characterization and antibacterial activity of copper, nickel and bimetallic Cu-Ni nanoparticles for potential use in dental materials. Prog. Nat. Sci. Mater. Int. 2014, 24, 321–328. [Google Scholar] [CrossRef]
- Brayner, R.; Ferrari-Iliou, R.; Brivois, N.; Djediat, S.; Benedetti, M.F.; Fievet, F. Toxicological impact studies based on escherichia coli bacteria in ultrafine ZnO nanoparticles colloidal medium. Nano Lett. 2006, 6, 866–870. [Google Scholar] [CrossRef] [PubMed]
- Jaisai, M.; Baruah, S.; Dutta, J. Paper modified with ZnO nanorods—antimicrobial studies. Beilstein J. Nanotechnol. 2012, 3, 684–691. [Google Scholar] [CrossRef] [PubMed]
- Tam, K.H.; Djurisic, A.B.; Chan, C.M.N.; Xi, Y.Y.; Tse, C.W.; Leung, Y.H.; Chan, W.K.; Leung, F.C.C.; Au, D.W.T. Antibacterial activity of ZnO nanorods prepared by a hydrothermal method. Thin Solid Films 2008, 516, 6167–6174. [Google Scholar] [CrossRef]
- Ahmad, R.; Mohsin, M.; Ahmad, T.; Sardar, M. Alpha amylase assisted synthesis of TiO2 nanoparticles: Structural characterization and application as antibacterial agents. J. Hazard. Mater. 2015, 283, 171–177. [Google Scholar] [CrossRef] [PubMed]
- Karunakaran, C.; Rajeswari, V.; Gomathisankar, P. Antibacterial and photocatalytic activities of sonochemically prepared ZnO and Ag-ZnO. J. Alloys Compd. 2010, 508, 587–591. [Google Scholar] [CrossRef]
- Ghosh, S.; Goudar, V.S.; Padmalekha, K.G.; Bhat, S.V.; Indi, S.S.; Vasan, H.N. Zno/Ag nanohybrid: Synthesis, characterization, synergistic antibacterial activity and its mechanism. RSC Adv. 2012, 2, 930–940. [Google Scholar] [CrossRef]
- Hassan, M.S.; Amna, T.; Sheikh, F.A.; Al-Deyab, S.S.; Choi, K.E.; Hwang, I.H.; Khil, M.-S. Bimetallic Zn/Ag doped polyurethane spider net composite nanofibers: A novel multipurpose electrospun mat. Ceram. Int. 2013, 39, 2503–2510. [Google Scholar] [CrossRef]
- Valodkar, M.; Modi, S.; Pal, A.; Thakore, S. Synthesis and anti-bacterial activity of Cu, Ag and Cu-Ag alloy nanoparticles: A green approach. Mater. Res. Bull. 2011, 46, 384–389. [Google Scholar] [CrossRef]
- Banerjee, M.; Sharma, S.; Chattopadhyay, A.; Ghosh, S.S. Enhanced antibacterial activity of bimetallic gold-silver core-shell nanoparticles at low silver concentration. Nanoscale 2011, 3, 5120–5125. [Google Scholar] [CrossRef] [PubMed]
- Sharma, N.; Kumar, J.; Thakur, S.; Sharma, S.; Shrivastava, V. Antibacterial study of silver doped zinc oxide nanoparticles against staphylococcus aureus and bacillus subtilis. Drug Inv. Today 2013, 5, 50–54. [Google Scholar] [CrossRef]
- Cohen, D.; Soroka, Y.; Ma’or, Z.; Oron, M.; Portugal-Cohen, M.; Brégégère, F.M.; Berhanu, D.; Valsami-Jones, E.; Hai, N.; Milner, Y. Evaluation of topically applied copper(II) oxide nanoparticle cytotoxicity in human skin organ culture. Toxicol. In Vitro 2013, 27, 292–298. [Google Scholar] [CrossRef] [PubMed]
- Moschini, E.; Gualtieri, M.; Colombo, M.; Fascio, U.; Camatini, M.; Mantecca, P. The modality of cell–particle interactions drives the toxicity of nanosized CuO and TiO2 in human alveolar epithelial cells. Toxicol. Lett. 2013, 222, 102–116. [Google Scholar] [CrossRef] [PubMed]
- Lei, M.; Liang, C.; Huan, Q.; Miyabayashi, K.; Miyake, M.; Yang, T. Morphology-controlled growth of Pt nanoparticles taking advantage of smaller molecule and inorganic salt. Acta Mater. 2014, 63, 202–208. [Google Scholar] [CrossRef]
- Goldman, E.R.; Medintz, I.L.; Whitley, J.L.; Hayhurst, A.; Clapp, A.R.; Uyeda, H.T.; Deschamps, J.R.; Lassman, M.E.; Mattoussi, H. A hybrid quantum dot-antibody fragment fluorescence resonance energy transfer-based TNT sensor. J. Am. Chem. Soc. 2005, 127, 6744–6751. [Google Scholar] [CrossRef] [PubMed]
- Daniel, M.C.; Astruc, D. Gold nanoparticles: Assembly, supramolecular chemistry, quantum-size-related properties, and applications toward biology, catalysis, and nanotechnology. Chem. Rev. 2004, 104, 293–346. [Google Scholar] [CrossRef] [PubMed]
- Escobedo-Lozano, A.Y.; Domard, A.; Velázquez, C.A.; Goycoolea, F.M.; Argüelles-Monal, W.M. Physical properties and antibacterial activity of chitosan/acemannan mixed systems. Carbohydr. Polym. 2015, 115, 707–714. [Google Scholar] [CrossRef]
- Kara, F.; Aksoy, E.A.; Yuksekdag, Z.; Hasirci, N.; Aksoy, S. Synthesis and surface modification of polyurethanes with chitosan for antibacterial properties. Carbohydr. Polym. 2014, 112, 39–47. [Google Scholar] [CrossRef] [PubMed]
- Tayel, A.A.; Moussa, S.; Opwis, K.; Knittel, D.; Schollmeyer, E.; Nickisch-Hartfiel, A. Inhibition of microbial pathogens by fungal chitosan. Int. J. Biol. Macromol. 2010, 47, 10–14. [Google Scholar] [CrossRef] [PubMed]
- Uemura, T.; Kitagawa, S. Prussian blue nanoparticles protected by poly(vinylpyrrolidone). J. Am. Chem. Soc. 2003, 125, 7814–7815. [Google Scholar] [CrossRef] [PubMed]
- Fu, H.B.; Yao, J.N. Size effects on the optical properties of organic nanoparticles. J. Am. Chem. Soc. 2001, 123, 1434–1439. [Google Scholar] [CrossRef]
- Ou, Z.-M.; Yao, H.; Kimura, K. Preparation and optical properties of organic nanoparticles of porphyrin without self-aggregation. J. Photochem. Photobiol. A Chem. 2007, 189, 7–14. [Google Scholar] [CrossRef]
- Navari-Izzo, F.; Quartacci, M.F.; Sgherri, C. Lipoic acid: A unique antioxidant in the detoxification of activated oxygen species. Plant. Physiol. Biochem. 2002, 40, 463–470. [Google Scholar] [CrossRef]
- Szelag, M.; Mikulski, D.; Molski, M. Quantum-chemical investigation of the structure and the antioxidant properties of alpha-lipoic acid and its metabolites. J. Mol. Model. 2012, 18, 2907–2916. [Google Scholar] [CrossRef] [PubMed]
- Demir, U.; Demir, T.; Ilhan, N. The protective effect of alpha-lipoic acid against oxidative damage in rabbit conjunctiva and cornea exposed to ultraviolet radiation. Ophthalmologica 2005, 219, 49–53. [Google Scholar] [CrossRef] [PubMed]
- Anand, N.; Ramudu, P.; Reddy, K.H.P.; Rao, K.S.R.; Jagadeesh, B.; Babu, V.S.P.; Burri, D.R. Gold nanoparticles immobilized on lipoic acid functionalized SBA-15: Synthesis, characterization and catalytic applications. Appl. Catal. A Gen. 2013, 454, 119–126. [Google Scholar] [CrossRef]
- Ghanizadeh, A. Gold nanoparticles and lipoic acid as a novel anti-inflammatory treatment for autism, a hypothesis. J. Med. Hypotheses Ideas 2012, 6, 40–43. [Google Scholar] [CrossRef]
- Guler, E.; Barlas, F.B.; Yavuz, M.; Demir, B.; Gumus, Z.P.; Baspinar, Y.; Coskunol, H.; Timur, S. Bio-active nanoemulsions enriched with gold nanoparticle, marigold extracts and lipoic acid: In vitro investigations. Colloids Surf. B Biointerfaces 2014, 121, 299–306. [Google Scholar] [CrossRef] [PubMed]
- Henderson, L.C.; Altimari, J.M.; Dyson, G.; Servinis, L.; Niranjan, B.; Risbridger, G.P. A comparative assessment of α-lipoic acid N-phenylamides as non-steroidal androgen receptor antagonists both on and off gold nanoparticles. Bioorg. Chem. 2012, 40, 1–5. [Google Scholar] [CrossRef] [PubMed]
- Leu, J.-G.; Chen, S.-A.; Chen, H.-M.; Wu, W.-M.; Hung, C.-F.; Yao, Y.-D.; Tu, C.-S.; Liang, Y.-J. The effects of gold nanoparticles in wound healing with antioxidant epigallocatechin gallate and α-lipoic acid. Nanomedicine: Nanomedicine Nanotechnol. Biol. Med. 2012, 8, 767–775. [Google Scholar] [CrossRef]
- Valodkar, M.; Rathore, P.S.; Jadeja, R.N.; Thounaojam, M.; Devkar, R.V.; Thakore, S. Cytotoxicity evaluation and antimicrobial studies of starch capped water soluble copper nanoparticles. J. Hazard. Mater. 2012, 201–202, 244–249. [Google Scholar] [CrossRef] [PubMed]
- Kim, E.J.; Yeum, J.H.; Choi, J.H. Effects of polymeric stabilizers on the synthesis of gold nanoparticles. J. Mater. Sci. Technol. 2014, 30, 107–111. [Google Scholar] [CrossRef]
- Navarro, J.R.G.; Pluggae, M.; Loumaigne, M.; Sanchez-Gonzalez, A.; Menucci, B.; Débarre, A.; Brower, A.M.; Werts, M.H.V. Probing interaction between disulfide-based ligands and gold nanoparticles using functionalised fluorescent perylene-monoimide dye. Photochem. Photobiol. Sci. 2010, 9, 1042–1054. [Google Scholar] [CrossRef] [PubMed] [Green Version]
- Rafiee, A.; Alimohammadian, M.H.; Gazori, T.; Riazi-rad, F.; Fatemi, S.M.R.; Parizadeh, A.; Haririan, I.; Havaskary, M. Comparison of chitosan, alginate and chitosan/alginate nanoparticles with respect to their size, stability, toxicity and transfection. Asian Pac. J. Trop. Dis. 2014, 4, 372–377. [Google Scholar] [CrossRef]
- Horovitz, O.; Tomoaia-Cotişel, M.; Racz, C.; Tomoaia, G.; Bobos, L.-D.; Mocanu, A. The interaction of silver nanoparticles with lipoic acid. Stud. Univ. Babes-Bolyai Chem. 2009, 54, 89–96. [Google Scholar]
- Gedde, U. Polymer Physics; Chapman & Hall: London, UK, 1995. [Google Scholar]
- De Almeida, C.G.; Garbois, G.D.; Amaral, L.M.; Diniz, C.C.; Le Hyaric, M. Relationship between structure and antibacterial activity of lipophilic N-acyldiamines. Biomed. Pharmacother. 2010, 64, 287–290. [Google Scholar] [CrossRef] [PubMed]
- Fernandes, P.; Ferreira, B.S.; Cabral, J.M.S. Solvent tolerance in bacteria: Role of efflux pumps and cross-resistance with antibiotics. Int. J. Antimicrob. Agents 2003, 22, 211–216. [Google Scholar] [CrossRef] [PubMed]
- Lambert, P.A. Cellular impermeability and uptake of biocides and antibiotics in gram-positive bacteria and mycobacteria. J. Appl. Microbiol. 2002, 92, 46S–54S. [Google Scholar] [CrossRef] [PubMed]
- Rai, M.K.; Deshmukh, S.D.; Ingle, A.P.; Gade, A.K. Silver nanoparticles: The powerful nanoweapon against multidrug-resistant bacteria. J. Appl. Microbiol. 2012, 112, 841–852. [Google Scholar] [CrossRef] [PubMed]
- Sondi, I.; Salopek-Sondi, B. Silver nanoparticles as antimicrobial agent: A case study on E. colias a model for Gram-negative bacteria. J. Colloid Interface Sci. 2004, 275, 177–182. [Google Scholar] [CrossRef] [PubMed]
- Klueh, U.; Wagner, V.; Kelly, S.; Johnson, A.; Bryers, J.D. Efficacy of silver-coated fabric to prevent bacterial colonization and subsequent device-based biofilm formation. J. Biomed. Mater. Res. 2000, 53, 621–631. [Google Scholar] [CrossRef] [PubMed]
- Lok, C.N.; Ho, C.M.; Chen, R.; He, Q.Y.; Yu, W.Y.; Sun, H.Z.; Tam, P.K.H.; Chiu, J.F.; Che, C.M. Proteomic analysis of the mode of antibacterial action of silver nanoparticles. J. Proteome Res. 2006, 5, 916–924. [Google Scholar] [CrossRef] [PubMed]
- Pal, S.; Tak, Y.K.; Song, J.M. Does the antibacterial activity of silver nanoparticles depend on the shape of the nanoparticle? A study of the gram-negative bacterium escherichia coli. Appl. Environ. Microbiol. 2007, 73, 1712–1720. [Google Scholar] [CrossRef] [PubMed]
- Gogoi, S.K.; Gopinath, P.; Paul, A.; Ramesh, A.; Ghosh, S.S.; Chattopadhyay, A. Green fluorescent protein-expressing escherichia coli as a model system for investigating the antimicrobial activities of silver nanoparticles. Langmuir 2006, 22, 9322–9328. [Google Scholar] [CrossRef] [PubMed]
- He, D.; Dorantes-Aranda, J.J.; Waite, T.D. Silver nanoparticle-algae interactions: Oxidative dissolution, reactive oxygen species generation and synergistic toxic effects. Environ. Sci. Technol. 2012, 46, 8731–8738. [Google Scholar] [CrossRef] [PubMed]
- Jones, A.M.; Garg, S.; He, D.; Pham, A.N.; Waite, T.D. Superoxide-mediated formation and charging of silver nanoparticles. Environ. Sci. Technol. 2011, 45, 1428–1434. [Google Scholar] [CrossRef] [PubMed]
- He, D.; Jones, A.M.; Garg, S.; Pham, A.N.; Waite, T.D. Silver nanoparticle-reactive oxygen species interactions: Application of a charging−discharging model. J. Phys. Chem. C 2011, 115, 5461–5468. [Google Scholar] [CrossRef]
- Lavi, R.; Shainberg, A.; Friedmann, H.; Shneyvays, V.; Rickover, O.; Eichler, M.; Kaplan, D.; Lubart, R. Low energy visible light induces reactive oxygen species generation and stimulates an increase of intracellular calcium concentration in cardiac cells. J. Biol. Chem. 2003, 278, 40917–40922. [Google Scholar] [CrossRef] [PubMed]
- Lavi, R.; Shainberg, A.; Shneyvays, V.; Hochauser, E.; Isaac, A.; Zinman, T.; Friedmann, H.; Lubart, R. Detailed analysis of reactive oxygen species induced by visible light in various cell types. Lasers Surg. Med. 2010, 42, 473–480. [Google Scholar] [CrossRef] [PubMed]
- Ankri, R.; Friedman, H.; Savion, N.; Kotev-Emeth, S.; Breitbart, H.; Lubart, R. Visible light induces nitric oxide (NO) formation in sperm and endothelial cells. Lasers Surg. Med. 2010, 42, 348–352. [Google Scholar] [CrossRef] [PubMed]
- Gudkov, S.V.; Karp, O.E.; Garmash, S.A.; Ivanov, V.E.; Chernikov, A.V.; Manokhin, A.A.; Astashev, M.E.; Yaguzhinsky, L.S.; Bruskov, V.I. Generation of reactive oxygen species in water under exposure of visible or infrared irradiation at absorption band of molecular oxygen. Biofizika 2012, 57, 5–13. [Google Scholar] [PubMed]
- Lubart, R.; Lavie, R.; Friedmann, H.; Sinyakov, M.; Shainberg, A.; Breitbart, H.; Grossman, N. UVA and visible light-induced reactive oxygen species (ROS) formation in cell cultures: An electron paramagnetic resonance (EPR) study. In Effects of Low-Power Light on Biological Systems V; Karu, T.L., Lubart, R., Eds.; SPIE: Amsterdam, The Netherlands, 2000; Volume 1, pp. 18–24. [Google Scholar]
- Park, H.-J.; Kim, J.Y.; Kim, J.; Lee, J.-H.; Hahn, J.-S.; Gu, M.B.; Yoon, J. Silver-ion-mediated reactive oxygen species generation affecting bactericidal activity. Water Res. 2009, 43, 1027–1032. [Google Scholar] [CrossRef] [PubMed]
- Jose Ruben, M.; Jose Luis, E.; Alejandra, C.; Katherine, H.; Juan, B.K.; Jose Tapia, R.; Miguel Jose, Y. The bactericidal effect of silver nanoparticles. Nanotechnology 2005, 16, 2346. [Google Scholar] [CrossRef] [PubMed]
- He, D.; Garg, S.; Waite, T.D. H2O2-mediated oxidation of zero-valent silver and resultant interactions among silver nanoparticles, silver ions, and reactive oxygen species. Langmuir 2012, 28, 10266–10275. [Google Scholar] [CrossRef] [PubMed]
- Shahverdi, A.R.; Fakhimi, A.; Shahverdi, H.R.; Minaian, S. Synthesis and effect of silver nanoparticles on the antibacterial activity of different antibiotics against staphylococcus aureus and escherichia coli. Nanomed. Nanotechnol. Biol. Med. 2007, 3, 168–171. [Google Scholar] [CrossRef]
- Matsumura, Y.; Yoshikata, K.; Kunisaki, S.-I.; Tsuchido, T. Mode of bactericidal action of silver zeolite and its comparison with that of silver nitrate. Appl. Environ. Microbiol. 2003, 69, 4278–4281. [Google Scholar] [CrossRef] [PubMed]
- Neal, A. What can be inferred from bacterium-nanoparticle interactions about the potential consequences of environmental exposure to nanoparticles? Ecotoxicology 2008, 17, 362–371. [Google Scholar] [CrossRef] [PubMed]
- Mylon, S.E.; Sun, Q.; Waite, T.D. Process optimization in use of zero valent iron nanoparticles for oxidative transformations. Chemosphere 2010, 81, 127–131. [Google Scholar] [CrossRef] [PubMed]
- Joo, S.H.; Feitz, A.J.; Sedlak, D.L.; Waite, T.D. Quantification of the oxidizing capacity of nanoparticulate zero-valent iron. Environ. Sci. Technol. 2005, 39, 1263–1268. [Google Scholar] [CrossRef] [PubMed]
- Wu, B.; Huang, R.; Sahu, M.; Feng, X.Y.; Biswas, P.; Tang, Y.J. Bacterial responses to Cu-doped TiO2 nanoparticles. Sci. Total Environ. 2010, 408, 1755–1758. [Google Scholar] [CrossRef] [PubMed]
- Bokare, A.; Sanap, A.; Pai, M.; Sabharwal, S.; Athawale, A.A. Antibacterial activities of Nd doped and Ag coated TiO2 nanoparticles under solar light irradiation. Colloid Surf. B-Biointerfaces 2013, 102, 273–280. [Google Scholar] [CrossRef]
- Jayanthi, N.; Cruz, J.; Pandiyan, T. DFT studies on the phenol and thiophenol interaction on an undecagold cluster surface. Chem. Phys. Lett. 2008, 455, 64–71. [Google Scholar] [CrossRef]
- Autschbach, J. Calculating electronical optical activity of coordination compounds. In Comprehensive Inorganic Chemistry II—From Elements to Applications, 2nd ed.; Elsevier: Amsterdam, The Netherlands; Waltham, MA, USA, 2013; Volume 9, pp. 407–426. [Google Scholar]
- Furche, F.; Rappoport, D. Density functional methods for excitated states: Equilibrium structure and electronic spectra. Theor. Comput. Chem. 2005, 16, 93–128. [Google Scholar]
- Choho, K.; Langenaeker, W.; VandeWoude, G.; Geerlings, P. Local softness and hardness as reactivity indices in the fullerenes C24–C76. J. Mol. Struct. THEOCHEM 1996, 362, 305–315. [Google Scholar] [CrossRef]
- Jalbout, A.F.; Darwish, A.M.; Alkahby, H.Y. Part II. Ionization energies, hardness, softness, and absolute electronegativity of heteronuclear and homonuclear diatomic molecules by the CBS-QB3 and G3B3 methods. J. Mol. Struct. THEOCHEM 2002, 585, 205–208. [Google Scholar] [CrossRef]
- Bhalla, V.; Gupta, A.; Kumar, M. Fluorescent nanoaggregates of pentacenequinone derivate for sensing of picric acid in aqueous media. Org. Lett. 2012, 14, 3112–3115. [Google Scholar] [CrossRef] [PubMed]
- Balows, A.; Hausler, W.J. Manual of Clinical Microbiology, 5th ed.; American Society for Microbiology: Washington, DC, USA, 1991. [Google Scholar]
- Coyle, M.B. Manual of Antimicrobial Susceptibility Testing; American Society for Microbiology: Seattle, WA, USA, 2005. [Google Scholar]
- Eloff, J.N. A sensitive and quick microplate method to determine the minimal inhibitory concentration of plant extracts for bacteria. Planta Med. 1998, 64, 711–713. [Google Scholar] [CrossRef] [PubMed]
- Marrie, T.J.; Costerton, J.W. Scanning and transmission electron-microscopy of insitu bacterial-colonization of intravenous and intraarterial catheters. J. Clin. Microbiol. 1984, 19, 687–693. [Google Scholar] [PubMed]
- Sample Availability: Samples of the compounds are available from the authors.
© 2015 by the authors. Licensee MDPI, Basel, Switzerland. This article is an open access article distributed under the terms and conditions of the Creative Commons Attribution license ( http://creativecommons.org/licenses/by/4.0/).
Share and Cite
Aguilar, C.A.H.; Jiménez, A.B.P.; Silva, A.R.; Kaur, N.; Thangarasu, P.; Ramos, J.M.V.; Singh, N. Organic-Inorganic Hybrid Nanoparticles for Bacterial Inhibition: Synthesis and Characterization of Doped and Undoped ONPs with Ag/Au NPs. Molecules 2015, 20, 6002-6021. https://doi.org/10.3390/molecules20046002
Aguilar CAH, Jiménez ABP, Silva AR, Kaur N, Thangarasu P, Ramos JMV, Singh N. Organic-Inorganic Hybrid Nanoparticles for Bacterial Inhibition: Synthesis and Characterization of Doped and Undoped ONPs with Ag/Au NPs. Molecules. 2015; 20(4):6002-6021. https://doi.org/10.3390/molecules20046002
Chicago/Turabian StyleAguilar, Carlos Alberto Huerta, Adriana Berenice Pérez Jiménez, Antonio Romero Silva, Navneet Kaur, Pandiyan Thangarasu, Jorge Manuel Vázquez Ramos, and Narinder Singh. 2015. "Organic-Inorganic Hybrid Nanoparticles for Bacterial Inhibition: Synthesis and Characterization of Doped and Undoped ONPs with Ag/Au NPs" Molecules 20, no. 4: 6002-6021. https://doi.org/10.3390/molecules20046002






